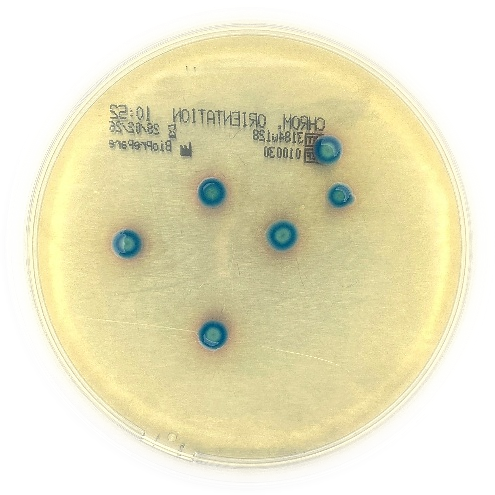
CHROMagar™ Orientation 2

CHROMagar™ Orientation 2
Το CHROMagar™ Orientation είναι ένα μη εκλεκτικό χρωμογενές θρεπτικό μέσο, σχεδιασμένο για την ποιοτική άμεση ανίχνευση, διαφοροποίηση και προγνωστική ταυτοποίηση των ουροπαθογόνων μικροοργανισμών, συμβάλλοντας στη διάγνωση των λοιμώξεων του ουροποιητικού συστήματος.